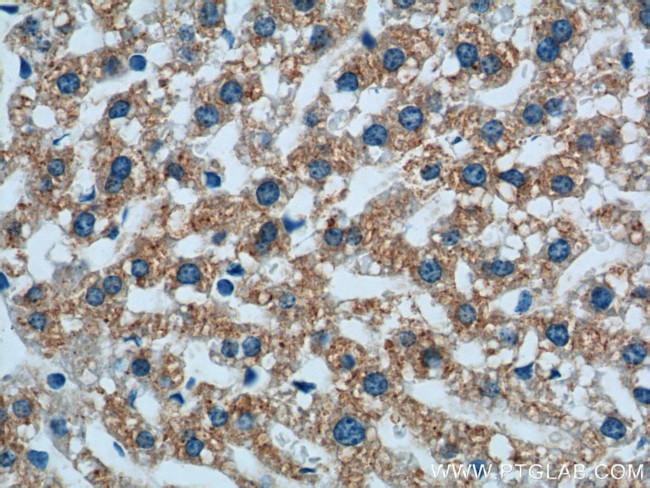
Prealbumin/transthyretin Antibody in Immunohistochemistry (Paraffin) (IHC (P))
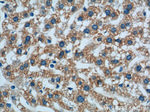
Prealbumin/transthyretin Antibody in Immunohistochemistry (Paraffin) (IHC (P))

Search
Proteintech
Prealbumin/transthyretin Monoclonal Antibody (1H8C4)
{{$productOrderCtrl.translations['antibody.pdp.commerceCard.promotion.promotions']}}
{{$productOrderCtrl.translations['antibody.pdp.commerceCard.promotion.viewpromo']}}
{{$productOrderCtrl.translations['antibody.pdp.commerceCard.promotion.promocode']}}: {{promo.promoCode}} {{promo.promoTitle}} {{promo.promoDescription}}. {{$productOrderCtrl.translations['antibody.pdp.commerceCard.promotion.learnmore']}}
产品信息
66108-1-IG
种属反应
宿主/亚型
分类
类型
克隆号
抗原
偶联物
形式
浓度
规格
纯化类型
保存液
内含物
保存条件
运输条件
产品详细信息
Immunogen sequence: MASHRLLLL CLAGLVFVSE AGPTGTGESK CPLMVKVLDA VRGSPAINVA VHVFRKAADD TWEPFASGKT SESGELHGLT TEEEFVEGIY KVEIDTKSYW KALGISPFHE HAEVVFTAND SGPRRYTIAA LLSPYSYSTT AVVTNPKE (1-147 aa encoded by BC020791)
靶标信息
Transthyretin (TTR), generally called prealbumin, is a plasma protein that plays an important role in physiology such as a transporter of hormone thyroxine and retinal-binding protein. After produced primarily in the liver, TTR is excreted into the plasma. TTR represents a disproportionate fraction (25%) of CSF protein, prompting the suggestion that it is either selectively transported across the blood-CSF barrier or synthesized de novo within the central nervous system. Transthyretin is a constituent found to the neuritic plaques, neurofibrillary tangles, and microangiopathic lesions of senile cerebral amyloid. It has been reported that more than 40 different mutations in the TTR gene associated with amyloid deposition.
仅用于科研。不用于诊断过程。未经明确授权不得转售。
生物信息学
蛋白别名: Amyloidosis I; ATTR; epididymis luminal protein 111; pre-albumin; Prealbumin; prealbumin, amyloidosis type I; TBPA; thyroxine-binding prealbumin; Transthyretin; TTR; unnamed protein product
基因别名: AA408768; AI787086; ATTR; CTS; CTS1; D17860; HEL111; HsT2651; PALB; prealbumin; TBPA; TTN; TTR
UniProt ID: (Human) P02766, (Mouse) P07309
Entrez Gene ID: (Human) 7276, (Mouse) 22139